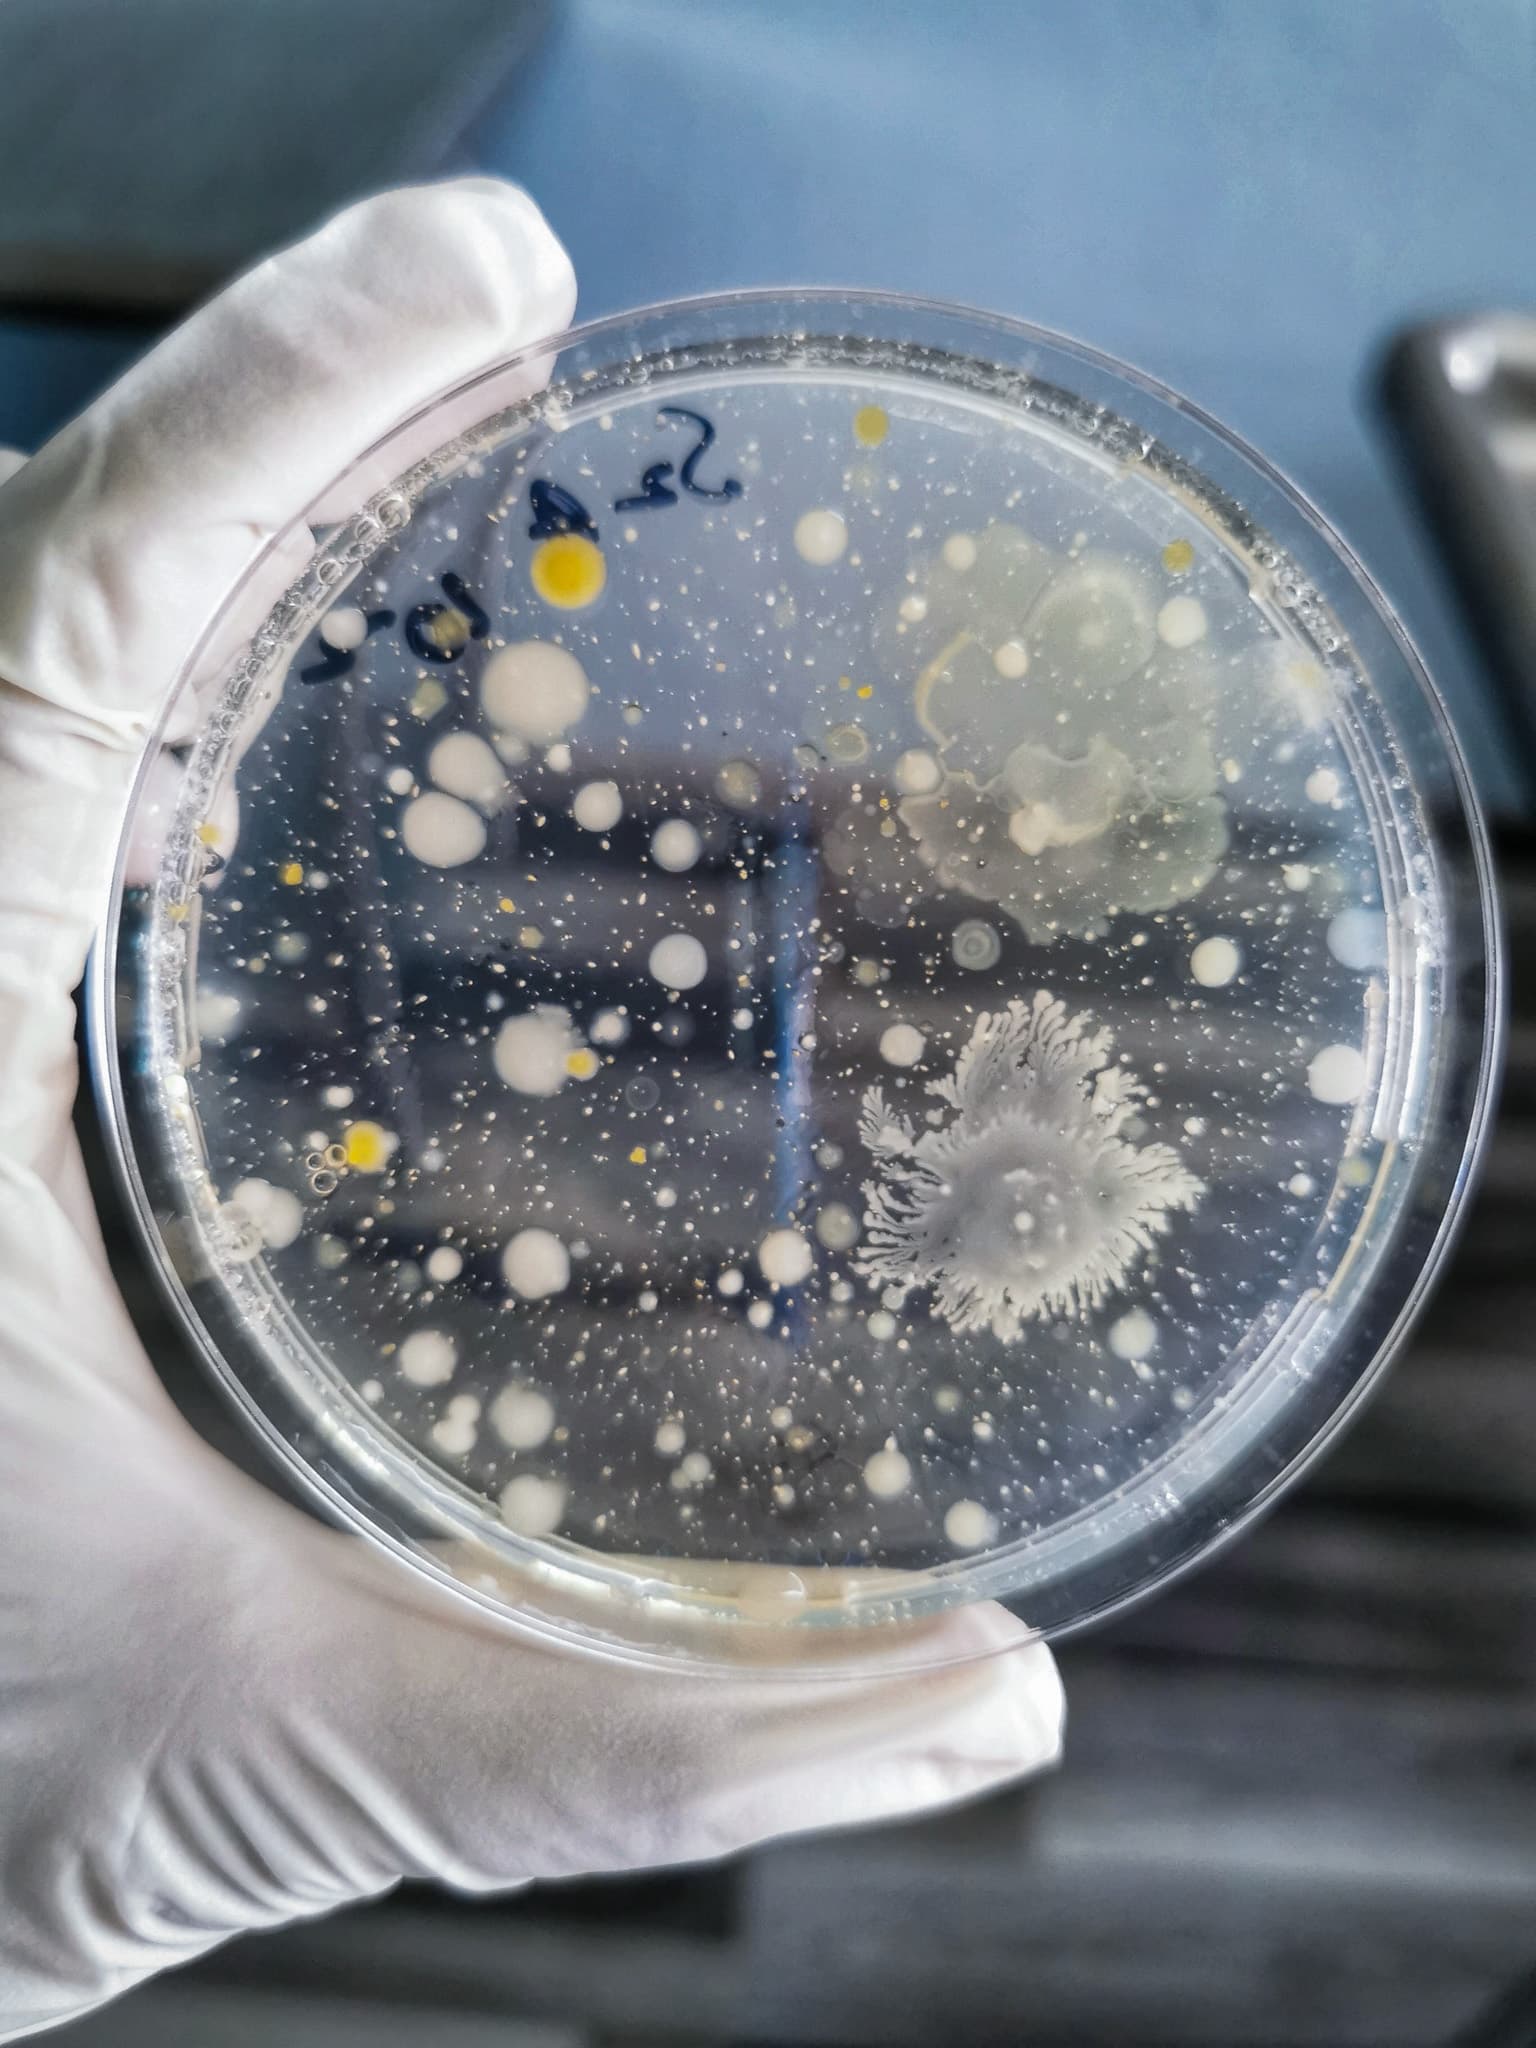
Microbial Growth on Agar Plate – Bioburden Testing

Is Vaporized Hydrogen Peroxide (VH2O2) the Right Sterilization Method for Your Medical Device?

By Jeffrey Chuang, Principal Microbiologist, LSO
When selecting a sterilization method for your medical device, material compatibility is a critical factor. Vaporized Hydrogen Peroxide (VH2O2, VHP) is a widely used low-temperature sterilization method known for its efficiency in eliminating microorganisms while being safer for the environment compared to ethylene oxide (EtO, EO). However, VH2O2 is not suitable for all materials. Using the wrong sterilization method can compromise product integrity, performance, and patient safety. In this guide, we explore VH2O2 material compatibility and provide a diagnostic tool to help you determine if VH2O2 is the right choice, or if an alternative sterilization method—such as gamma, electron beam (e-beam), EtO, or steam—is more appropriate.
Understanding VH2O2 Material Compatibility
VH2O2 sterilization is highly effective for heat- and moisture-sensitive materials. However, it is not suitable for all device components. Common concerns include:
- Material Degradation: Certain plastics and elastomers may weaken, become brittle, or discolor. Non-surgical grade metals can oxidize or rust.
- Surface Reactions: Some materials may absorb or react with hydrogen peroxide, leading to unwanted changes.
- Residual Presence: The potential for retained VH2O2 in porous materials can be problematic.
Materials that are generally compatible with VH2O2 sterilization: ✅ Polypropylene (PP), ✅ Polyethylene (PE), ✅ Polycarbonate (PC) (with some limitations), ✅ Stainless steel, ✅ Titanium, ✅ Most glass materials Materials that are not recommended for VH2O2 sterilization: ❌ Nylon (absorbs hydrogen peroxide, leading to material degradation), ❌ Certain adhesives and coatings (may weaken or delaminate), ❌ Natural rubber and some silicone elastomers (can be degraded by VH2O2 exposure), ❌ Cellulose-based materials (incompatible due to peroxide reactivity), ❌ Acetal (Delrin®) (severe effects).
Diagnostic Tool: Is VH2O2 the Right Sterilization Method for Your Device?
Answer the following questions to determine whether VH2O2 is the best sterilization choice, or if an alternative method would be more suitable. [wpforms id="11121"]
When to Consider Other Sterilization Methods
If your responses indicate VH2O2 is not the best fit, consider the following alternatives:
- In-House Ethylene Oxide (EtO): Best for electronics, devices with complex lumens, heat-sensitive components, and porous materials. LSO provides in-house EtO sterilization with full validation and regulatory support. For highly successful products, LSO partners with vendors to quickly scale up production.
- In-House Steam Sterilization: The preferred method for high-heat-resistant medical devices and instruments. LSO offers in-house steam sterilization, ensuring efficient processing for autoclave-compatible materials. LSO offers the largest contracted autoclave on the West Coast, with 74 cu ft capacity. Smaller chambers are also available.
- Managed Gamma Sterilization: Ideal for bulk sterilization of compatible polymers and pre-packaged items. LSO can facilitate gamma sterilization as a managed service.
- Managed Electron Beam (E-Beam): Fast sterilization for radiation-compatible materials with minimal processing time. LSO provides e-beam sterilization through trusted partners.
LSO Sterilization Services
At Life Science Outsourcing (LSO), we offer comprehensive in-house EtO and steam sterilization services, along with managed access to gamma and e-beam sterilization to meet your specific requirements. Our sterilization experts can help you select the best method based on material compatibility, regulatory requirements, and performance considerations. Need Help Choosing the Right Sterilization Method? Speak with one of our sterilization experts today or read a summary of different sterilization methods here.